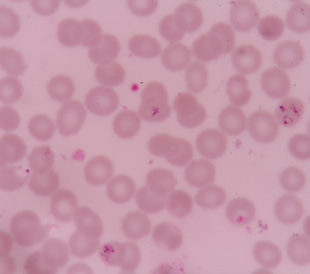
Plasmodium falciparum infections red blood cells. Image: plenoy m/Shutterstock.com.

Researchers—particularly those interested in tracking cancer mutations—apply the proteogenomic approach to shotgun proteomics data for the purpose of mining relevant information hidden therein. To do this, they search tandem mass spectra against a customized database comprising proteins with residue substitutions. This enables the identification of proteins with single amino acid substitutions, generally unidentified by shotgun methods alone.
One challenging identification involves tryptic peptides whose sequences contain threonine (Thr) and isothreonine (isoThr). The latter residue can be mistaken for a methionine (Met) substitution arising as an artifact of sample preparation. However, this substitution, unlike a point mutation, is not encoded in the genome. Distinguishing between the two without ambiguity is imperative for protein discovery applications.
For this reason, Kuznetsova et al. (2016) presented an approach for recognizing Met/isoThr conversion as a product of sample preparation, using tandem mass spectrometry fragmentation patterns to distinguish between threonine and isothreonine.1 The team analyzed 72 human tryptic peptides (36 peptides and their Thr/isoThr analogues) and 15 model peptide pairs as controls. They used an UltiMate 3000 RSLCnano system coupled with a Q Exactive HF Hybrid Quadrupole-Orbitrap mass spectrometer (both Thermo Scientific) to produce spectral data. They manually inspected the raw files with Xcalibur Qual Browser software, revision 2.2, SP1.48, (Thermo Scientific) before processing the data with MaxQuant, using the Andromeda peptide search engine against a customized database of sequences derived from the human and model peptide groups.
The researchers first looked at retention times. They found an average difference of 1.26 minutes when comparing retention times for peptides containing threonine versus isothreonine. They also observed that the average retention time for threonine-containing peptides and isothreonine-containing peptides for the set of sequences containing only one threonine residue was significantly smaller than the average retention time for peptides with multiple threonine residues (0.77 minutes versus 1.58 minutes).
For all peptides, those containing isothreonine eluted earlier than those containing threonine. However, the observed retention time differences for analogous peptides were smaller than their differences with the retention times determined using a prediction model. This means that these peptides can only be differentiated using retention times if studied in analogous pairs.
Kuznetsova et al. hypothesized that higher energy collisional dissociation (HCD) fragmentation pattern differences should allow unambiguous discrimination of threonine- and isothreonine-containing peptides. Using relative intensities of product ions, they selected six characteristic ions (bn, bn–2, yn, yn–1, yn–2 and yn+1) and analyzed which feature or combination of features provided the most accurate discrimination between threonine and isothreonine. Ultimately, they report that bn alone classified with high accuracy (84 ± 2.4%) with no increase in accuracy arising from the addition of other features.
Overall, the research team presents their approach as a method capable of unambiguously separating peptide pairs containing threonine isoforms. Kuznetsova et al. combined retention models for peptide pairs with the relative peak intensity of the b-product ion in the HCD spectra for increased accuracy. They are confident that this enhancement increases the method’s value for potential applications, including protein discovery and point mutation tracking.
References
1. Kuznetsova, K.G., et al. (2016) “Threonine versus isothreonine in synthetic peptides analyzed by high-resolution liquid chromatography/tandem mass spectrometry,” Rapid Communications in Mass Spectrometry, 30(11) (pp. 1323–1331), doi: 10.1002/rcm.7566.

Leave a Reply